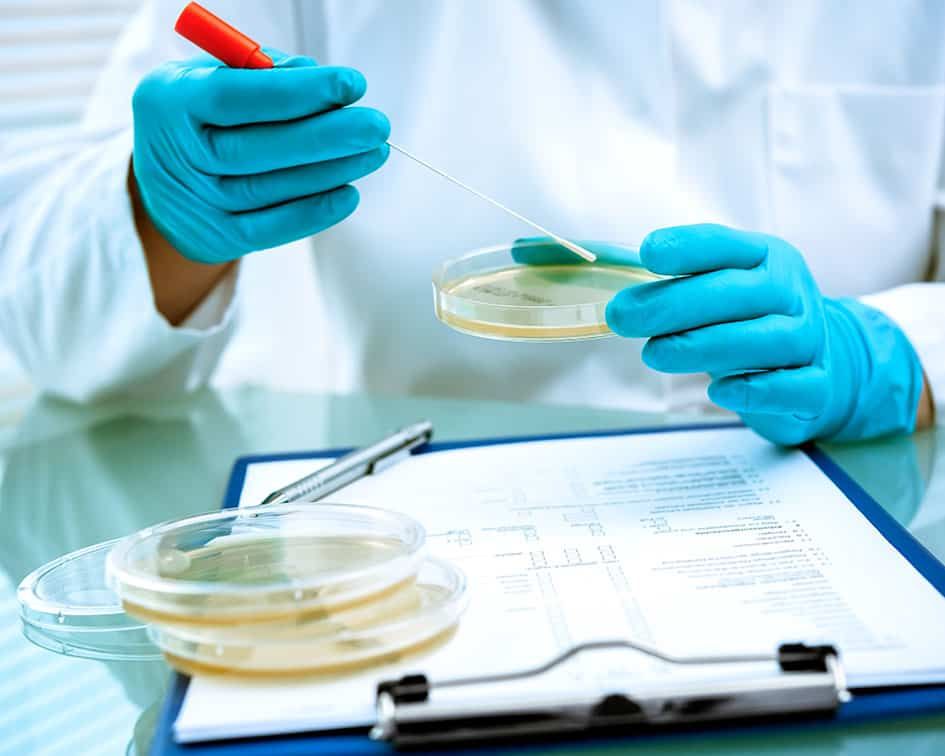
Uno scienziato tiene in mano una capsula di Petri e una pipetta sopra un blocco appunti.

MICRO.BIOS
Il laboratorio di analisi cliniche MicroBios è una struttura moderna situata a Palermo che effettua una vasta gamma di indagini cliniche, microbiologiche, batteriologiche, allergologiche e citologiche.
MICRO.BIOS
Il laboratorio di analisi cliniche Micro.Bios è una struttura moderna situata a Palermo che effettua una vasta gamma di indagini cliniche, microbiologiche, batteriologiche, allergologiche e citologiche.
Servizi
Scopri i nostri servizi di analisi cliniche: un approccio su misura per la tua salute.
Analisi di Base
Microbiologia e Infettivologia
Endocrinologia e Ormoni
Allergologia e Intolleranze
Analisi Genetiche e Molecolari
Analisi di Base
Microbiologia e Infettivologia
Endocrinologia e Ormoni
Allergologia e Intolleranze
Analisi Genetiche e Molecolari
Servizi
Scopri i nostri servizi di analisi cliniche: un approccio su misura per la tua salute.
Analisi di Base
Microbiologia e Infettivologia
Endocrinologia e Ormoni
Allergologia e Intolleranze
Analisi Genetiche e Molecolari
Analisi di Base
Microbiologia e Infettivologia
Endocrinologia e Ormoni
Intolleranze
Analisi Genetiche e Molecolari
Chi siamo
Il laboratorio di analisi cliniche MicroBios nasce a Palermo nel 1992 organizzato e gestito dallla Dott.ssa. Eugenia Ventimiglia. Il laboratorio essendo in possesso di nuove tecnologie in ambito biochimico-analitico garantisce l’emissione delle risposte analitiche con la massima attenzione ed attendibilità dei risultati prescindendo dall'impegno tecnico. Nel corso degli anni l'attività è stata ampliata in vari settori analitici al servizio dell'utenza privata e delle aziende.
Chi siamo
Il laboratorio di analisi cliniche Micro.Bios nasce a Palermo nel 1992 organizzato e gestito dallla Dott.ssa. Eugenia Ventimiglia. Il laboratorio essendo in possesso di nuove tecnologie in ambito biochimico-analitico garantisce l’emissione delle risposte analitiche con la massima attenzione ed attendibilità dei risultati prescindendo dall'impegno tecnico. Nel corso degli anni l'attività è stata ampliata in vari settori analitici al servizio dell'utenza privata e delle aziende.
Prelievi a domicilio
Hai bisogno di fare un prelievo del sangue ma non hai tempo di recarti in laboratorio? Microbios ha la soluzione perfetta per te! Grazie al nostro servizio di prelievi personalizzati a domicilio su prenotazione da lunedì al venerdì, potrai effettuare gli esami di cui hai bisogno nel comfort di casa tua. Il nostro personale qualificato ti seguirà passo dopo passo per garantirti un'esperienza comoda e professionale. Non rinunciare alla tua salute per mancanza di tempo, affidati a Microbios per prelievi sicuri e affidabili direttamente a casa tua.
Prelievi a domicilio
Hai bisogno di fare un prelievo del sangue ma non hai tempo di recarti in laboratorio? Micro.Bios ha la soluzione perfetta per te! Grazie al nostro servizio di prelievi personalizzati a domicilio su prenotazione da lunedì al venerdì, potrai effettuare gli esami di cui hai bisogno nel comfort di casa tua. Il nostro personale qualificato ti seguirà passo dopo passo per garantirti un'esperienza comoda e professionale. Non rinunciare alla tua salute per mancanza di tempo, affidati a Micro.Bios per prelievi sicuri e affidabili direttamente a casa tua.
Prelievi per i più piccoli
Da Microbios, il nostro personale qualificato e competente si prenderà cura dei vostri piccoli, offrendo un servizio ottimale in ogni situazione. Ci assicuriamo che i vostri bambini siano trattati con cura e attenzione, garantendo risultati accurati ed affidabili. Al laboratorio di analisi cliniche Microbios, comprendiamo l'importanza di avere fiducia nei professionisti che si occupano della salute dei vostri piccoli e ci impegniamo a offrire il miglior servizio possibile.
Prelievi per i più piccoli
Da Micro.Bios, il nostro personale qualificato e competente si prenderà cura dei vostri piccoli, offrendo un servizio ottimale in ogni situazione. Ci assicuriamo che i vostri bambini siano trattati con cura e attenzione, garantendo risultati accurati ed affidabili. Al laboratorio di analisi cliniche Micro.Bios, comprendiamo l'importanza di avere fiducia nei professionisti che si occupano della salute dei vostri piccoli e ci impegniamo a offrire il miglior servizio possibile.